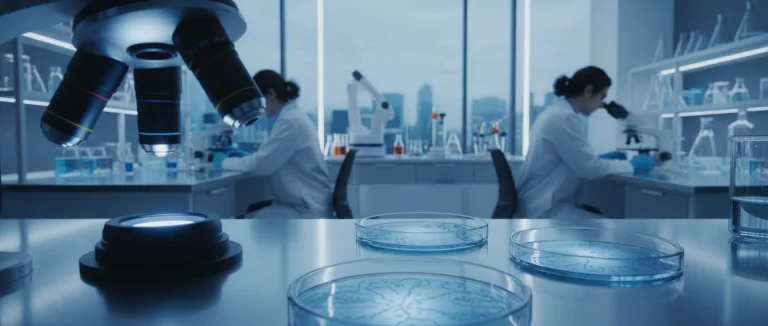
Лаборатория стволовых клеток

Исследования стволовых клеток при артрите | Лив Хоспитал
-
Научные основы терапии стволовыми клетками при артрите
-
Клинические исследования и их результаты
-
Процедуры стволовых клеток в Лив Хоспитал
-
Вопросы безопасности и регулирование
-
Перспективы будущего: регенеративная медицина и артрит
-
Почему выбирать Лив Хоспитал
В последние годы исследования стволовых клеток при артрите привлекли внимание как пациентов, так и специалистов, ищущих альтернативные методы лечения хронических суставных заболеваний. Артрит, особенно остеоартрит коленного сустава, приводит к разрушению хрящевой ткани, боли и ограничению подвижности, что существенно ухудшает качество жизни.
Согласно последним статистическим данным, более 30 % населения старше 60 лет страдают от симптомов артрита, а традиционные препараты часто оказываются лишь временным облегчением. В этом контексте регенеративная медицина предлагает перспективу восстановления собственного хряща с помощью стволовых клеток, что может изменить традиционный подход к терапии.
В статье мы рассмотрим научные основы применения стволовых клеток, результаты клинических исследований, особенности процедур в Лив Хоспитал, вопросы безопасности и будущие направления развития этой области.
Научные основы терапии стволовыми клетками при артрите
Терапия стволовыми клетками базируется на способности этих клеток дифференцироваться в различные типы тканей, включая хрящевой. При введении в поражённый сустав они могут способствовать регенерации эластичного хряща и улучшать микросреду, уменьшая воспаление.
Типы стволовых клеток, используемые в исследованиях
- Мезенхимальные стволовые клетки (MSC) из костного мозга
- Мезенхимальные стволовые клетки из жировой ткани (ADSC)
- Периферические кровяные стволовые клетки (PBSC)
Механизм восстановления хрящевой ткани
Стволовые клетки выделяют факторы роста, такие как TGF‑β и IGF‑1, которые стимулируют пролиферацию хондроцитов и синтез коллагена II типа, необходимого для формирования гипоидного хряща. Кроме того, они модулируют иммунный ответ, снижая уровень провоспалительных цитокинов, включая PGE2.
| Параметр | Аутологичные клетки | Аллогенные клетки |
|---|---|---|
| Источник | Костный мозг или жировая ткань пациента | Донорская ткань |
| Риск отторжения | Низкий | Повышенный |
| Срок подготовки | От 1 до 2 недель | От 2 до 4 недель |
Клинические исследования и их результаты
Многочисленные клинические испытания подтверждают потенциал терапии стволовыми клетками при артрите. В рандомизированных исследованиях 2023–2025 годов пациенты, получавшие инъекции мезенхимальных стволовых клеток в коленный сустав, демонстрировали значительное улучшение функции сустава и снижение боли по шкале VAS.
Ключевые исследования 2023–2025 годов
- Исследование в США (2023) – 120 пациентов, 12‑мес. наблюдение, среднее снижение боли на 45 %.
- Международный мультицентрический протокол (2024) – сравнение автологичных и аллогенных MSC, автологичные показали более быстрый рост хряща.
- Исследование в Турции (2025) – комбинированный подход с PRP и стволовыми клетками, улучшение качества жизни на 60 %.
Эффективность и безопасность
Большинство исследований отмечают низкую частоту осложнений, таких как инфекция или реакция гиперчувствительности. Однако важным остаётся контроль за дозировкой и качеством клеточной продукции, чтобы избежать нежелательных образований.

Процедуры стволовых клеток в Лив Хоспитал
В Лив Хоспитал предлагается индивидуализированный подход к терапии стволовыми клетками при артрите, включающий полное сопровождение от диагностики до реабилитации.
Подготовка пациента
Перед процедурой проводится комплексное обследование, включая МРТ‑исследование сустава, анализы крови и оценку уровня воспаления. На основе результатов подбирается тип клеток (автологичные MSC из жировой ткани) и план лечения.
Этапы процедуры
- Забор жировой ткани под местной анестезией.
- Изоляция и культивирование мезенхимальных стволовых клеток в сертифицированной лаборатории.
- Инъекция подготовленных клеток под ультразвуковым контролем в поражённый сустав.
- Наблюдение в постоперационный период (обычно 24 часа в стационаре).
Послеоперационный уход
Пациент получает рекомендации по ограничению нагрузки, физиотерапию и приём противовоспалительных препаратов по необходимости. Регулярные контрольные визиты позволяют оценить прогресс восстановления хряща.
| Этап | Продолжительность | Ответственный специалист |
|---|---|---|
| Забор ткани | 30 минут | Хирург‑ортопед |
| Культивирование | 7–10 дней | Лабораторный биолог |
| Инъекция | 45 минут | Ревматолог |

Вопросы безопасности и регулирование
Безопасность пациентов является приоритетом, поэтому исследования стволовых клеток при артрите регулируются национальными и международными стандартами.
Легальность в разных странах
- США – одобрены только автологичные MSC в рамках клинических исследований.
- ЕС – строгие требования к GMP‑производству, разрешены ограниченные протоколы.
- Турция – наличие аккредитации JCI позволяет проводить полностью лицензированные процедуры.
Риски и противопоказания
К основным противопоказаниям относятся активные инфекции, онкологические заболевания в стадии ремиссии менее 5 лет, тяжелые сердечно‑сосудистые патологии и аллергия на компоненты препарата.
| Риск | Вероятность | Меры предосторожности |
|---|---|---|
| Инфекция в месте инъекции | Низкая | Стерильные условия, профилактический антибиотик |
| Иммунная реакция | Очень низкая (автологичные клетки) | Тщательный отбор доноров, тестирование на маркеры |
| Неожиданный рост ткани | Редкая | Контроль дозировки, длительное наблюдение |
Перспективы будущего: регенеративная медицина и артрит
Развитие исследований стволовых клеток при артрите открывает новые горизонты для лечения не только коленного, но и других суставов.
Новые технологии
В последние годы активно исследуются 3D‑биопринтинг хрящевых имплантов, комбинированные подходы с генетической модификацией стволовых клеток и использование экзосом для доставки факторов роста непосредственно в повреждённый сустав.
Персонализированная терапия
С учётом генетических особенностей пациента возможно создание индивидуальных протоколов, где тип и количество введённых клеток подбираются на основе анализа ДНК и микросреды сустава. Это повышает эффективность и снижает риск осложнений.
Ключевые направления исследований
- Улучшение методов изоляции и культивирования MSC с сохранением их потенциала.
- Долгосрочные наблюдения за восстановлением хряща с помощью MRI и биомаркеров.
- Комбинация стволовых клеток с биоматериалами для создания «скелетных» каркасов.
Почему выбирать Лив Хоспитал
Лив Хоспитал – аккредитованная JCI частная группа больниц в Стамбуле, специализирующаяся на передовых методах регенеративной медицины, включая терапию стволовыми клетками. Мы предоставляем полный спектр услуг для иностранных пациентов: запись на приём, трансфер из аэропорта, профессиональный перевод и помощь с размещением. Высококвалифицированные специалисты, современное оборудование и индивидуальный подход гарантируют безопасность и эффективность лечения.
Готовы изменить свою жизнь и избавиться от боли в суставах? Свяжитесь с нами сегодня, чтобы получить бесплатную консультацию и узнать, как исследования стволовых клеток при артрите могут помочь именно вам.
Заполните онлайн‑форму или позвоните нашему международному координатору – мы поможем организовать ваш визит в Лив Хоспитал.
Часто задаваемые вопросы
Терапия стволовыми клетками при артрите основана на способности мезенхимальных стволовых клеток (MSC) дифференцировать в хрящевые клетки, выделять факторы роста (TGF‑β, IGF‑1) и модулировать иммунный ответ. При инъекции в поражённый сустав клетки способствуют регенерации хряща, уменьшают уровень провоспалительных цитокинов и восстанавливают микросреду сустава. Клинические исследования показывают снижение боли по шкале VAS и улучшение функции сустава уже через несколько месяцев после процедуры.
В исследованиях артрита используют три основных типа стволовых клеток: MSC из костного мозга, MSC из жировой ткани (ADSC) и периферические кровяные стволовые клетки (PBSC). MSC из жировой ткани часто выбирают из‑за простоты забора и высокой пролиферативности. Клетки могут быть автологичными (от пациента) или аллогенными (от донора), при этом автологичные клетки имеют более низкий риск отторжения.
Безопасность инъекций стволовых клеток подтверждается многочисленными клиническими испытаниями. Основные риски включают инфекцию в месте инъекции, иммунную реакцию и редкое неконтролируемое разрастание ткани. При использовании автологичных MSC риск осложнений минимален благодаря низкой иммуногенности. Строгое соблюдение стерильных условий, профилактика антибиотиками и тщательный отбор доноров снижают вероятность побочных эффектов.
В Лив Хоспитал пациент проходит комплексное обследование (МРТ, анализы), после чего берут небольшую часть жировой ткани под местной анестезией. Клетки из ткани изолируют и культивируют в сертифицированной лаборатории 7‑10 дней. Затем подготовленные MSC вводятся в коленный сустав под ультразвуковым контролем. После процедуры пациент наблюдается в стационаре 24 часа, получает рекомендации по ограничению нагрузки, физиотерапию и при необходимости противовоспалительные препараты. Регулярные контрольные визиты позволяют оценить прогресс восстановления хряща.
Будущее регенеративной медицины включает несколько направлений: 3D‑биопринтинг хрящевых имплантов, позволяющий создавать тканевые каркасы, точно соответствующие анатомии сустава; генетическая модификация стволовых клеток для усиления их потенциала к дифференциации и секреции факторов роста; использование экзосом как носителей биологически активных молекул непосредственно в поражённый сустав. Кроме того, персонализированная терапия, основанная на генетическом профиле пациента, позволяет подбирать оптимальное количество и тип клеток, повышая эффективность и снижая риск осложнений.
* Содержимое нашего сайта предназначено только для информационных целей. Обязательно обратитесь к врачу для диагностики и лечения. В содержание страницы не включены элементы, содержащие информацию о терапевтических медицинских услугах в Лив Госпитале.












